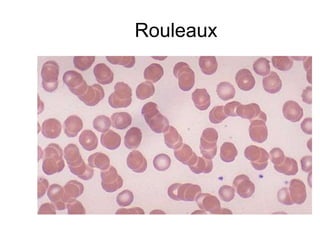
Rouleaux

This document provides an overview of shock and hemorrhage for EMT students. It defines shock as inadequate tissue perfusion that can result from injury or illness. It describes the stages of hemorrhage based on percentage of blood volume lost, associated signs and symptoms, and management strategies. It also reviews concepts like oxygen transport, cellular metabolism, circulation, and cardiovascular system regulation to provide context for understanding shock pathophysiology.